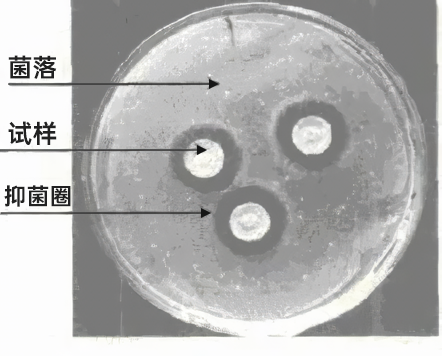

谈到头皮健康,我们或多或少都有过头皮屑的困扰。
头皮每天都在更新脱落,少量的头屑属于正常的皮肤代谢。但如果莫名出现头屑明显过多、头痒,说明头皮健康可能出现问题,也许是头皮上的马拉色菌在作祟!
如何抑制马拉色菌、改善头屑问题?让我们一探究竟,完美去屑组合物将给你答案。

跟肠道菌群类似,我们皮肤表面的微生物也与人体维持着微妙的平衡,其中马拉色菌在人体皮肤上广泛存在,占头皮真菌总量的96%,目前已鉴定出有18个菌种。


(糠秕马拉色菌 (M. furfur) 镜下图 (上),皮肤刮片显示典型的菌丝和孢子簇 (下))
马拉色菌通常不致病,但如果因特殊情况侵入到角质层并顺利大量增殖,便可能引发各种皮肤问题,包括头皮屑增多和脂溢性皮炎等。
此外,马拉色菌还是一种嗜脂性真菌,其生长繁殖与头皮油脂的分泌情况息息相关。

在日用品领域,目前广泛用来抑制马拉色菌的原料有吡硫嗡锌 (ZPT)、水杨酸 (BHA) 等。
然而,由于潜在的健康风险,ZPT原料自2022年3月1日起在欧盟化妆品中被正式禁用;另外,水杨酸作为化妆品限用组分和准用防腐剂,我国法规对该成分有严格的使用规定。
因此,寻找天然、安全的替代原料,并筛选具有抑制马拉色菌活性的组合物,对改善头屑问题具有科学意义和实用价值。
组合物主要成分
根据大量前期调研,完美确认了扁柏酚具有广谱抗菌活性,并在此基础上将其与多种天然产物进行复配研究,最终确定下述去屑组合物的主要成分:

1.扁柏酚
又称桧木醇,由科学家于1948年从台湾扁柏的树干中提取,具有良好的抗菌性、保湿性,是高安全性的植物成分。

2.硫辛酸
在自然界广泛分布,动物体内肝脏和肾脏组织含量丰富,植物中含量较高的是西兰花,具有强大的抗氧化功能,是人体细胞能量代谢的必要因子。

3.γ-十一内酯
又称桃醛,是常用的内酯香料之一,天然品存于桃子、桂花、大豆水解蛋白、奶油等中。

4.γ-壬内酯
又称椰子醛,浓时有椰子香味,稀释后则有桃、杏、梨似的果香,天然品存于桃子、杏子、番茄等中。
主要成分抗抑菌效果
1.抑马拉色菌活性
完美采用抑菌圈法衡量成分的抑菌作用,通过观察并测量抑菌圈直径大小,可以初步判断微生物对药物的敏感性。
(抑菌圈试验示意图)
初步筛选显示,扁柏酚、硫辛酸、γ-十一内酯和γ-壬内酯均对马拉色菌有较强的抑菌活性。
表1 不同化合物对糠秕马拉色菌的
抑菌圈直径测量结果

2.最小抑菌浓度
基于上述结果,完美使用尿素肉汤二倍稀释法进一步测试原料的最小抑菌浓度(MIC)。
在下图试验中,从左到右孔药液浓度由高到低,黄色代表马拉色菌完全受抑制,紫红色代表马拉色菌活性高,培养48h后无颜色变化的最低药物浓度的那一孔即为MIC。

可以观察到,扁柏酚的MIC为第8列浓度 (从左往右数),使用相同方法可测试剩余三种天然产物的MIC。

(不同化合物对糠秕马拉色菌的MIC测试结果)
测试结果显示,扁柏酚的MIC值比较低,与常用来抑制马拉色菌的ZPT的MIC值达到了同一数量级,这表明扁柏酚具有较好的抗马拉色菌活性。
此外,硫辛酸、γ-十一内酯、γ-壬内酯也表现出一定的抗马拉色菌活性,具有一定的研究和应用价值。
扁柏酚抗抑菌效果增效研究
基于上述研究成果,完美进一步进行了多因素考察,并验证最终组合物的抑制马拉色菌效果。

安全评价
通过第三方机构测试,进行急性皮肤刺激性试验,结果显示为无刺激性;皮肤变态反应试验,结果显示为未见皮肤变态反应;皮肤光毒性试验,结果显示为未见皮肤光毒性;即完美去屑组合物安全、温和不刺激。

第三方机构安全性测试报告

完美利用抑菌圈法和最小抑菌浓度法,研究并测试了一种抑制马拉色菌的去屑组合物。
该去屑组合物以扁柏酚、硫辛酸、γ-十一内酯和γ-壬内酯四种天然产物为主要成分,通过科学实验数据证明有协同增效作用,具有最小抑菌浓度(MIC)低、安全性高的特点。
责编:樊汝琴
一审:樊汝琴
二审:喻志科
三审:熊佳斌
来源:新湖南客户端

湖南日报新媒体
